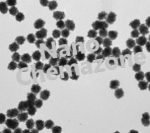
Platinum nanoparticles Dispersion Homogenized

Platinum Dispersion
$0.00
| MF: | Pt |
| Chemical Name: | Platinum Dispersion |
| Purity: | > 99.99% |
| APS: | 1-10 nm (Size Customization possible) |
| Form: | Nanopowder/Dispersion |
| Product Number: | NCZD901 |
| CAS Number | 7440-06-4 |
Please contact us for customization and price inquiry.
Note: We supply different size products of micro and Nano Size range dispersion according to client’s requirements.
Note: For pricing & ordering information, please contact us at sales@nanochemazone.com
Please contact us for quotes on Larger Quantities & Customization. E-mail: contact@nanochemazone.com
Customization:
If you are planning to order large quantities for your industrial and academic needs, please note that customization of parameters (such as size, length, purity, functionalities, etc.) are available upon request.
Other composition and customer’s specified configurations can be delivered upon request. Stabilizer, pH Value, Pack Size, and Contents of Artificial Lysosomal Fluid are customizable.
Contact us for Customization: sales@nanochemazone.com
Transportation and storage: Transportation at room temperature, storage at 4 ℃. For Longterm Storage Freeze it at -20 ℃






Related products
Aluminum Toluene Dispersion
| MF: | Al |
| Chemical Name: |
Aluminium Toluene Dispersion |
| Purity: | >99.99% |
| APS: | 80 nm (Size Customization possible) |
| Form: | Nanodispersion |
| Product Number: | NCZD201 |
| CAS Number | 7429-90-5 |
Antimony Tin Oxide Dispersion
| MF: | ATO |
| Chemical Name: |
Antimony Tin Oxide Dispersion |
| Purity: | >99.99% |
| APS: | 20-80 nm (Size Customization possible) |
| Form: | Nano dispersion |
| Product Number: | NCZD1501 |
| CAS Number | 128221-48-7 |
Calcium Carbonate Dispersion
| MF: | CaCO3 |
| Chemical Name: | Calcium Carbonate Dispersion |
| Purity: | >99.99% |
| APS: | < 80 nm (Size Customization possible) |
| Form: | Nanodispersion (Water, IPA, Ethanol) |
| Product Number: | NCZD301 |
| CAS Number | 471-34-1 |
Carbon Conductive Ink
| MF: | C |
| Chemical Name: |
Carbon Conductive Ink |
| Purity: | > 99.99% |
| APS: | 80-100 nm (Size Customization possible) |
| Form: | Ink |
| Product Number: | NCZD1601 |
| CAS Number | 7440-44-0 |
Gold Nanoparticles Dispersion
| MF: | Au |
| Chemical Name: | Gold Nanoparticles Dispersion |
| Purity: | >99.99% |
| APS: | <10nm (Size Customization possible) |
| Form: | Nano dispersion |
| Product Number: | NCZD601 |
| CAS Number | 7440-57-5 |
Silver Colloidal Dispersion
| MF: | Ag |
| Chemical Name: | Silver Colloidal Dispersion |
| Purity: | >99.99% |
| APS: | 20 nm (Size Customization possible) |
| Form: | Nano dispersion |
| Product Number: | NCZD1002 |
| CAS Number | 7440-22-4 |
Silver Copper Alloy Dispersion
| MF: | Ag |
| Chemical Name: | Silver Copper Alloy Dispersion |
| Purity: | >99.99% |
| APS: | <80 nm (Size Customization possible) |
| Form: | Nano dispersion/Nanopowder/ Dried Nanoparticles |
| Product Number: | NCZD1003 |
| CAS Number | 7440-22-4/7440-50-8 |
Silver Dispersion Nanoparticles
Silver Nanoparticles Dispersion
Colloidal Silver Dispersion
Silver Dispersion Nanoparticles
| MF: | Ag |
| Chemical Name: | Silver Dispersion Nanoparticles |
| Purity: | > 99.99% |
| APS: | 70 nm (Size Customization possible) |
| Form: | Nano dispersion |
| Product Number: | NCZD1001 |
| CAS Number | 7440-22-4 |
The antibacterial effects of silver nanoparticles have been used to control bacterial growth in a variety of applications, including dental work, surgery applications, wounds and burns treatment, and biomedical devices. It is well known that silver ions and silver-based compounds are highly toxic to microorganisms.